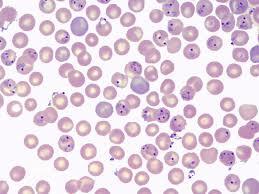

寄生蟲 | Parasites
HK$680.00
Product Details
Weight: 0.40 kg
如你有此疾病,請遵照閣下醫生的完整醫療方案;而是否使用多學科復康方案前,你必須咨詢主診醫生的意見,如果閣下的主診醫生不建議您加入補充劑調理組合,請你不要使用。如果你需要尋求其他醫生作第二咨詢,閣下可聯絡我們線上<無邊界醫生>或你自己城市內的其他專業醫生的再診斷。
寄生蟲
儘管許多疾病現在已經被根除,但某些疾病仍然存在,而另一些疾病則出現了。例如,現時的估計表明,每年有100萬至200萬人死於瘧疾(Crompton,1999年;Sachs&Malaney,2002年),2008年死於愛滋病相關疾病的人數相同(世界衛生組織[WHO],2010年)。此外,上述例子是基於致命性疾病,但許多非致命性傳染病對人類有害,並可能對其生殖成功產生負面影響。例如,考慮淋巴濾泡病,一種由蚊子傳播的嚴重寄生蟲病(主要是班氏絲蟲,占90%的感染,其次是馬來絲蟲和蒂莫裏絲蟲,占10%的感染)。Melrose(2002年)報告說,大約有1.2億人,主要分佈在非洲、南美洲和其他一些國家
亞熱帶地區(見Michael、Bundy和Grenfell,1996)受到感染。儘管並非所有感染者都受到這些蠕蟲的明顯影響(Grove,1983),但如果表達出來,感染者的四肢、陰囊或其他身體部位都會大大增大。這些人被更廣泛的社區所回避(Badaki,2010)。注意,肺吸蟲病不能通過身體接觸如肺結核或流感在人與人之間傳播。囙此,可以說,儘管某些寄生蟲,包括那些與人類關係更密切的寄生蟲(也被稱為“完美寄生蟲”,參見Kaplan,2010)不是致命的,但它們可能影響人類的生殖成功,囙此,它們也可能影響人類的思維。另外兩個證據在這一論點中是有效的:首先,人們懷疑那些現在被認為是“完美寄生蟲”的寄生蟲(例如絛蟲牛帶絛蟲,猪帶絛蟲)對人類的危害相對較小,因為殺死它們的最終宿主由於自身能力的限制是不適應的(Kaplan,2010).然而,這表明,一種特定寄生蟲與我們的祖先初次接觸可能會產生嚴重的健康後果,這可能是對相對無害的寄生蟲,如絛蟲(絛蟲屬)或蛔蟲(蛔蟲)的負面看法的原因(Curtis,Aunger,&Rabie,2004;Prokop&Fančovičová,2010年;Prokop、Usak和Fančovičová,2010b)。其次,“完美寄生蟲”被認為對人類的危害較小,特別是在我們現時的環境中,那裡的食物供應量很高,但在資源匱乏的工業化國家,情况就不同了。
例如,蛔蟲病,由蛔蟲引起,是世界上最常見的寄生蟲病之一。總的來說,約25%的人口受到感染(Berger&Marr,2006),但非洲貧困地區的感染率接近100%(Berger&Marr,2006;Kaplan,2010).儘管感染者可能仍然無症狀,但與營養缺乏和腸梗阻相關的嚴重蠕蟲感染有時是致命的(Kaplan,2010;Baird,Marthy,Pimsler和Connor,1986)。
這些例子說明了這樣一個事實:寄生蟲無處不在,而且很可能對我們的進化史產生了不可忽視的影響。
寄生蟲-多學科研證復康方案
- 藥物及其他醫療方案,請遵醫從醫生建議
- 飲食營養請依營養師指引
- 運動及或心理輔導,請參考各專家建議
- 為免錯誤診斷及漏診,請上傳最近一個月醫院的專業診斷報告,如證實是此症,則可參加試用期不如意退款計劃#。
可能適合的補充劑支援:
標準組合:
- 試用時期: 4星期
# <試用期不如意退款計劃>,請參考相關文件
本產品並非根據《藥劑業及毒藥條例》或《中醫藥條例》注册。任何對其提出的索賠均不受此類登記評估的約束。本產品不用於診斷、治療或預防任何疾病。
If you have this disease, please follow your doctor's complete medical plan. You must consult the attending doctor before using the multidisciplinary rehabilitation plan. If your attending doctor does not recommend you to join the supplement conditioning combination, please do not use it. If you need to seek second opinion from other doctors, you can contact our online "Doctors Without Borders", or another professional doctor in your own city.
Parasites
Although many diseases have now been eradicated, certain diseases still persist whilst others emerge. For example, current estimates suggest that one to two million people die from malaria annually (Crompton, 1999; Sachs & Malaney, 2002) and the same number of people died in 2008 due to diseases associated with AIDS (World Health Organization [WHO], 2010). Furthermore, the aforementioned examples are based on lethal diseases, but many non-lethal infectious diseases are harmful to humans and can negatively infl uence their reproductive success. Consider, for example, lymphatic fi lariasis, a serious parasitic disease caused by roundworms (mainly Wuchereria bancrofti, which accounts for 90% of infections, and to a lesser degree Brugia malayi and Brugia timori, which account for the remaining 10% of infections) spread by mosquitoes – vectors of the disease. Melrose (2002) reported that about 120 million people, primarily in Africa, South America and certain other subtropical areas (see Michael, Bundy, & Grenfell, 1996), are infected are infected. Although not all infected people suffer any obvious effects from these worms (Grove, 1983), if expressed, infected individuals have enormously enlarged limbs, scrotum or other body parts. These people are shunned and avoided by the wider community (Badaki, 2010). Note that fi lariasis cannot be transmitted from human to human by physical contact like tuberculosis or infl uenza. Thus, it can be argued that although certain parasites, including those that have a closer relationship with humans (also called “perfect parasites”, cf. Kaplan, 2010), are not lethal, they could affect human reproductive success and, as a result, they could also infl uence the human mind. Two additional pieces of evidence are valid in this argument: fi rstly, it is suspected that those parasites now considered as “perfect parasites” (e.g., tapeworms Taenia saginata, Taenia solium) are relatively less harmful to humans, because killing their fi nal host is maladaptive due to the restriction of their own fi tness (Kaplan, 2010). This, however, suggests that the initial contact of a particular parasite with our ancestors could have serious health consequences that would perhaps account for the negative perception of relatively non-harmful parasites such as tapeworms (Taenia spp.) or roundworms (Ascaris lumbricoides) (Curtis, Aunger, & Rabie, 2004; Prokop & Fančovičová, 2010; Prokop, Usak, & Fančovičová, 2010b). Secondly, “perfect parasites” are considered less harmful to humans, particularly in our current environment, where food availability is high, but the situation in industrialised countries with low resources is different. For example, ascariasis, caused by the roundworm A. lumbricoides, is one of most common parasitic diseases in the world. Overall, about 25% of the human population is infected (Berger & Marr, 2006), but the rates of infection in poor areas of Africa are close to 100% (Berger & Marr, 2006; Kaplan, 2010). Although infected individuals could remain asymptomatic, heavy worm infestation, associated with nutritional defi ciency and obstruction of the bowels, is sometimes fatal (Kaplan, 2010; Baird, Mistrey, Pimsler, & Connor, 1986).
However, these examples illustrate the fact that parasites are ubiquitous and most probably had non-trivial effects on our evolutionary history.
Multidisciplinary research and rehabilitation program for Parasites
- Please follow the doctor's advice for drugs and other medical plans
- Please follow the guidance of nutritionist
- For sports or psychological counseling, please refer to the experts' suggestions
- In order to avoid misdiagnosis and missed diagnosis, please upload the professional diagnosis report of the hospital in the latest month. If it is confirmed to be this disease, you can participate in the <Unsatisfactory Refund Scheme during the Trial Period>.#
Possible supplements supporting:
Standard combination:
Trial period: 4 weeks
# Please refer to the relevant documents for the <Unsatisfactory Refund Scheme during the Trial Period>
Products are not registered under the Pharmacy and Poisons Ordinance or the Chinese Medicine Ordinance. Any claim made for it has not been subject to evaluation for such registration. This product is not intended to diagnose, treat or prevent any disease.